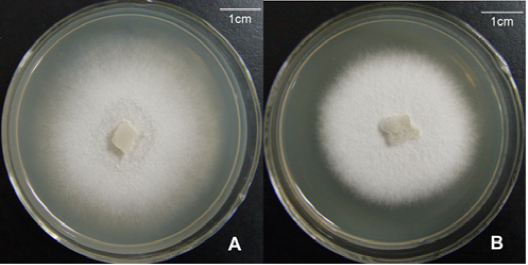

为进一步提高《微生物组实验手册》稿件质量,本项目新增大众评审环节。文章在通过同行评审后,采用公众号推送方式分享全文,任何人均可在线提交修改意见。公众号格式显示略有问题,建议电脑端点击文末阅读原文下载PDF审稿。在线文档(https://kdocs.cn/l/cL8RRqHIL)大众评审页面登记姓名、单位和行号索引的修改建议。修改意见的征集截止时间为推文发布后的72小时,文章将会结合有建设性的修改意见进一步修改后获得DOI在线发表,同时根据贡献程度列为审稿人或致谢。感谢广大同行提出宝贵意见。
为进一步提高《微生物组实验手册》稿件质量,本项目新增大众评审环节。文章在通过同行评审后,采用公众号推送方式分享全文,任何人均可在线提交修改意见。公众号格式显示略有问题,建议电脑端点击文末阅读原文下载PDF审稿。在线文档(https://kdocs.cn/l/cL8RRqHIL)大众评审页面登记姓名、单位和行号索引的修改建议。修改意见的征集截止时间为推文发布后的72小时,文章将会结合有建设性的修改意见进一步修改后获得DOI在线发表,同时根据贡献程度列为审稿人或致谢。感谢广大同行提出宝贵意见。
树木共生真菌菌株纯化及快速鉴定方法
Method for Purification and Rapid Identification of Tree Associated Symbiotic of Fungi
韦焕深1,2,袁志林1,2 *
1 林木遗传育种国家重点实验室,中国林业科学研究院,北京
2 中国林业科学研究院亚热带林业研究所,杭州
*通讯作者邮箱: yuanzl@caf.ac.cn
摘要: 树木共生真菌筛选是研究林木共生真菌资源收集重要的途径,但是在共生真菌的筛选过程中出现会出现多种共生真菌杂生或不产生繁殖结构等问题,为树木共生真菌的筛选与鉴定带来许多问题。共生真菌的纯化和快速鉴定在富集共生真菌资源中十分重要。本文从树木共生真菌纯化与鉴定两方面,利用转接和悬浮液纯化的方法,富集培养获得纯化的共生真菌;基于形态描述与分子生物学相结合的的方法鉴定菌株的分类地位。
关键词:共生真菌,菌株纯化,分子鉴定,形态描述
材料与试剂
1.分析纯乙醇(国药集团化学试剂有限公司,沪试,产品目录号:80176961)
2.分析纯丙三醇(国药集团化学试剂有限公司,沪试,产品目录号:10010618)
3.次氯酸钠(国药集团化学试剂有限公司,沪试,产品目录号:80010428)
4.冰醋酸(国药集团化学试剂有限公司,沪试,产品目录号:L01099402)
5.Oxoid™ Malt Extract(Thermo Scientific™,OXOID,产品目录号: LP0039B)
6.马铃薯,胡萝卜(超市购买)
7.纯净水(超纯水)
8.琼脂糖(北京鼎国昌盛生物技术有限责任公司,Genview,产品目录号:9012-36-6)
9.Tris(北京鼎国昌盛生物技术有限责任公司,Genview,产品目录号:77-86-1)
10.葡萄糖(上海麦克林生化科技有限公司,麦克林,产品目录号:D810588)
11.琼脂粉(北京鼎国昌盛生物技术有限责任公司,DING GOU,产品目录号: DH010-1.1)
12.ITS通用引物以及其他引物订购(北京擎科新业生物技术有限公司,杭州合成 部)
13.PBS粉末(生工生物工程(上海)股份有限公司,BBI,产品目录号:PD0100)
14.玉米粉琼脂(生物风,ELITE-MEDIA,产品目录号: M307-01)
15.硫酸链霉素(Genview公司,Genview,产品目录号:3810-74-0)
16.盐酸强力霉素(上海麦克林生化科技有限公司,麦克林,产品目录号:D807503)
17.真菌基因组DNA试剂盒(北京艾德莱科技生物有限公司,艾德莱,产品目录号:DN4102)
18.绿如蓝核酸染料(北京百奥莱博科技有限公司,百奥莱博,产品目录号:BTN70303)
仪器设备
1.无菌涂布棒
2.接种针
3.一次性培养皿
4.1.5 ml无菌离心管
5.1.8 ml塑料冷冻管
6.无纺纱布
7.50 ml离心管(BD Falcon)
8.10 ml 离心管
9.10ml无菌注射器
10.封口膜 (Polisciences Inc公司,Parafilm,catalog number: PM996)
11.不同规格的钢珠(2 mm、4 mm)
12.不同规格枪头(蓝色枪头,黄色枪头,白色枪头,10ml或5ml枪头)
13.155mm的得力剪刀
14.新星高级擦镜纸(杭州特种纸业有限公司,杭州,规格10×15cm)美的电磁炉
15.容量约为5 L的普通锅
16.超净工作台(苏净集团苏州安泰空气技术有限公司,苏州安泰,型号:SW-CJ-1FD)
17.霉菌培养箱(上海博讯实业有限公司医疗设备厂,型号:MJX-250B-Z型)
18.不锈钢酒精灯(国药集团化学试剂有限公司,产品目录号:CC-4566-03)
19.电泳仪设备(北京六一仪器厂,北京六一,产品型号:DYY-6C)
20.立式压力蒸汽灭菌器(上海申安医疗机器厂,申安,产品型号:LDZF-50KB-Ⅱ)
21.涡旋振荡器(MoBio公司,MoBio,产品型号:Vortex-Genie 2)
22.台式高速冷冻离心机(Sigma公司,Sigma,产品型号:3K15)
23.电子精密天平(上海民桥精密科学仪器有限公司,MINQIAO,产品型号:JA1103 FA/JA系列)
24.MyCycler PCR扩增仪(Bio-Rad公司,Bio-Rad,产品型号:MyCycler)
25.光学显微镜 (Carl Zeiss, Germany,产品型号:AxioScope A1)
26.雪科制冰机(常熟市雪科电器有限公司,雪科,产品型号: IMS-20)
27.冷冻切片机(Thermo,产品型号:Cryostar NX70)
软件和数据库
1.NCBI数据库BLAST(Basic Local Alignment Search Tool) (https://blast.ncbi.nlm.nih.gov/Blast.cgi)
2.BioEdit v7.2(https://bioedit.software.informer.com/7.2/)
3.GeneDoc v2.7.0(https://genedoc.software.informer.com/download/)
实验步骤
1.内生真菌的纯化
1.1转接纯化
采用尖端菌丝挑取法挑取边缘菌丝,转接入新鲜的PDA培养基中,于25 °C继续培养,待长出新菌落后,根据菌种的形态与颜色的不同,再次挑取尖端菌丝进行纯化,反复纯化至单一菌种。
1.2悬浮液纯化
根据内生真菌是否产生孢子等繁殖结构,可将悬浮液分为菌丝悬浮液(图1)和孢子悬浮液纯化(图2)。悬浮液纯化是对于部分生长速度相对一致或利用转接纯化不理想的真菌所进行的一种纯化方式。
1)菌丝悬浮液纯化
a.在超净工作台中,将无菌的,不同规格(2 mm、2.5 mm规格等)的钢珠3-4颗放入2 ml的无菌离心管中,加入2 ml的无菌水,将灼烧的接种针充分冷却(可在无菌的培养基平板或无菌水)刮取少量菌丝,用旋涡振荡器震荡5次,每次1min;使菌丝尽可能均匀的分散在无菌水中;
b.取干净2 ml无菌离心管,加入1.0 ml的无菌水,转移100 μl菌丝悬浮液至0.9 ml的无菌水中,上下颠倒混匀,连续稀释10倍;
c.转移稀释后取100 μl悬浮液至新鲜的PDA平板上,使用涂布棒均匀涂布,25 °C黑暗培养,每个样品梯度重复三个平板;
d.24 h(根据真菌本身生长速度,可调整)后开始观察,之后间隔3-5 h观察一次,发现单菌落或单根菌丝后转移至新鲜PDA培养基平板上,25 °C黑暗培养,获得单菌落,筛选纯的目标菌株。

图1. 内生真菌菌丝悬浮液的纯化过程
2)孢子悬浮液纯化
a.在超净工作台中,将培养4-5 d的菌落中加入5 ml无菌的蒸馏水,使用涂布棒来回摩擦菌落表面,吸取部分1(2 ml)菌液于装有9 ml(8 ml)无菌水的无菌离心管中,利用旋涡振荡器震荡涡旋2-3 min,混匀(可根据具体情况调整时间);
b.3层的无菌的擦镜纸过滤,除掉细小菌丝,转移滤液于10 ml的无菌离心管中,将所得的滤液涡旋震荡30 s-60 s,尽可能使孢子均匀分散;
c.取10 ml无菌离心管,加入9 ml的无菌水,转移1 ml孢子悬浮液至9 ml的无菌水中,上下颠倒4-5次,尽可能使孢子均匀分散,血球计数板计数(可根据孢子的浓度调整稀释次数),连续稀释10倍或100倍等;
d.吸100 μl稀释后悬浮液至新鲜的PDA平板上,使用涂布棒均匀涂布,25 °C黑暗培养,每个样品重复三个平板;
e.24 h后开始观察,之后间隔3-5 h观察一次,发现单菌落或单根菌丝后转移至新鲜平板上,25 °C黑暗培养,获得单菌落。

图2. 内生真菌孢子悬浮液纯化
2.内生真菌的鉴定
树木的内生真菌在不同的组织部位有明显的差别,而且不育菌株在内生真菌分离物中占有相当的比例(4.5%-45%),不同类型的内生真菌有不同的鉴定策略(图3)。在鉴定过程中主要以形态学的显微观察结合分子水平的系统发育关系的方法来鉴定,鉴定过程一般包括比较培养性状、孢子形态、载孢体等形态特征,并分析多标记基因的系统发育树。

图3. 内生真菌的鉴定策略(袁志林,2010)
2.1形态学鉴定
1)产孢群体
在形态学鉴定过程中,针对不同特性的真菌种类,所采用的鉴定策略也有差别。对于产孢群体(图4)鉴定过程:

图4. 产孢真菌Stagonosporopsis rhizophilae形态特征。在PDA (A),MEA(B),CA(C),OA(D)上培养7天的菌落照片;(E-F)分生孢子器;(G)分生孢子器壁; (H)产孢细胞;(I)分生孢子。标尺:2 cm (A-D); 800 μm(E); 20 μm(F); 10 μm(G-I)。
a.将真菌转接到PDA培养基上,25 °C培养适宜时间,在培养过程中观察真菌的宏观结构,如菌落形态,颜色质地,生长速度等;
b.培养一定时间后,观察显微结构如菌丝形态、分生孢子形态与大小,产孢结构等。根据形态结构查询工具书和相关文献资料将菌株鉴定到属或种的水平。
c.利用分子学证据支持其鉴定。具体步骤见2.2分子学鉴定。
2)不产孢群体
a.对于不产孢的内生真菌,进行诱导产孢。常见的诱导培养基有:麦芽汁培养基(MEA)、玉米粉培养基(CMA)、马铃薯胡萝卜培养基(PCA)和燕麦培养基(OA)等;或无菌的宿主组织上接种培养;或不同光源诱导,如紫光灯诱导等。
b.若诱导产孢成功,则根据产孢内生真菌的形态学鉴定方法进行鉴定。
c.若诱导产孢不成功,其鉴定过程主要以分子学鉴定为主,形态学鉴定为辅,如Muscodor yunnanense(图5)通过ITS和RPB2标记基因构建系统发育树鉴定(图6)。测定每个形态型中的代表菌株的多个标记基因的序列,进行Blast的比对,分析序列的相似性,确定大致的分类地位(目、科或属的地位),具体步骤见2.2分子学鉴定。
图5. 云南气霉菌株Muscodor yunnanense S18-3-1在PDA(A)和MEA(B)培养基生长的菌落特征(25 °C黑暗培养1周)[6]。

图6. 基于ITS基因片段建立NJ进化树分析云南产气霉与炭角菌科相关类群真菌的系统发育关系。Bootstrap值>50%显示在每个分支的节点上[6]。
2.2分子学鉴定
在共生真菌的鉴定过程中,分子学鉴定十分重要。对于产孢的共生真菌,首先选择经过可靠形态鉴定的物种为材料,然后测定其标记基因的序列,实现对该物种的DNA条形编码。对于不产孢共生真菌,首先观察现有的形态特征,然后选择标记基因,测定序列,进行Blast比对后,与其近缘种比较形态特征,从而鉴定纯培养物。这种方法简单快捷,越来越成为真菌鉴定首选方法。具体的标记基因鉴定过程如下:
1)内生真菌DNA提取。挑取纯培养真菌菌丝至1.5 ml无菌离心管中,并使用真菌基因组DNA快速提取试剂盒(艾德莱)并依据其操作说明书的步骤进行真菌DNA提取,具体步骤见说明书。
2)多标记基因PCR扩增。以内生真菌的DNA为模板,对内转录间隔区(ITS rDNA)基因片段进行PCR序列扩增。扩增体系50 μl:2μl模板DNA(约20-50 ng);正向与反向引物各0.5 μl(浓度50 μM);25 μl 2×Taq Master Mix(北京康为世纪生物科技有限公司),最后用无菌ddH2O补齐。所用引物名称以及PCR程序(见表1)。PCR扩增产物送往生工生物工程(上海)股份有限公司进行测序。
表1. 六个基因片段PCR扩增所用引物和扩增程序
目的片段 Fragments | 所用引物Primers | PCR程序 Amplification protocol | 参考文献 References |
ITS | ITS1F | (1)94 °C预变性4 min; (2)94 °C变性40 s,55 °C退火50 s, 72 °C延伸1 min,计35个循环; (3)72 °C延伸10 min | White et al., 1990[1] |
ITS4 | |||
SSU | NS1 | (1)94 °C预变性4 min; (2)94 °C变性40 s,55 °C退火50 s, 72 °C延伸2 min,计35个循环; (3)72 °C延伸10 min | White et al., 1990[1] |
NS4 | |||
LSU | LR0R | (1)94 °C预变性4 min; (2)94 °C变性40 s,55 °C退火50 s, 72 °C延伸2 min,计35个循环; (3)72 °C延伸10 min | Vilgalys and Hester, 1990[2] |
LR5 | |||
tef1 | EF1-983F | Touchdown PCR(递减PCR): (1)94 °C预变性4 min; (2)94 °C变性40 s,66 °C退火50 s, 72 °C延伸1.5 min,每个循环降低1 °C,计10个循环; (3)94 °C变性40 s,56 °C退火50 s, 72 °C延伸1.5 min,计30个循环 (4)72 °C延伸10 min | Rehner and Buckley, 2005[3] |
EF1-2218R | |||
RPB2 | fRPB2-5f | (1)94 °C预变性4 min; (2)94 °C变性50 s,58 °C退火50 s, 72 °C延伸2 min,计35个循环; (3)72 °C延伸10 min | Liu et al. 1999[4] |
fRPB2-7cR | |||
TUB | TUB2FD | (1)94 °C预变性5 min; (2)94 °C变性40 s,51°C退火1 min, 72 °C延伸1.5 min,计35个循环; (3)72 °C延伸10 min | Aveskamp et al. 2009[5] |
TUB4RD |
3)测序结果分析。测序结果经BioEdit v7.2、GeneDoc v2.7.0软件人工去除首尾参差不齐的部分序列,再通过NCBI网站进行BLAST(Basic Local Alignment Search Tool)比对(https://blast.ncbi.nlm.nih.gov/Blast.cgi),下载相关已发表模式菌株对应序列,并基于ITS序列对分离所得真菌分类地位进行初步鉴定。
4)系统发育树的分析。基于SSU、LSU、tef1、RPB2、和TUB等标记基因对待鉴定的真菌进行系统发育分析,所用引物名称以及PCR程序(见表1)。基于供试菌株的基因序列以及数据库中下载的参考菌株基因序列进行联合分析,并构建单基因和多基因系统发育树。
标记基因选择的标准:①选择具有较高保守性,在进化过程中能够容忍更多变异,在的绝大多数真核生物中表现极为广泛的序列多态性。②基因区序列在种内的不同个体之间变异小,但不同种之间存在足够大的差异,以便于区分不同的物种;③标记基因序列长度不易过长,便于在部分受损DNA样本中进行扩增和序列分析;④标记基因的数据库应足够大,包括足够多的真菌系统进化信息,便于不同分类等级生物物种的鉴别;⑤标记基因的引物通用性强、扩增成功率高;⑥对于不同的分类群可以用相同的DNA区域进行标准化操作。如ITS作为真菌DNA条形码的主要优势在于其大小合适(-500 bp),引物通用性强,扩增成功率高,而且在GenBank等数据库中存有最多的DNA片段序列。
目前对树木共生真菌的鉴定主要采用分子鉴定(ITS、LSU、RPB2等基因)结合形态描述(有性繁殖和无性繁殖结构)的方法;无论共生真菌是否产孢,我们均将根据系谱系统发育种类鉴别技术(Genealogical Concordance Phylogenetic Species Recognition,GCPSR)鉴定物种,对几个非连锁基因的系统发育进行分析,构建系统发育树(图5,图7)(单基因和多基因联合分析构建系统发育树,可选择的建树方法有最大简约法、最大似然法以及贝叶斯建树),每个真实种的系统发育位置至少有些是一致的,在其他种类中也是不矛盾,从而完成整个树木共生真菌的鉴定的工作。

图7. 基于RPB2基因片段建立NJ进化树分析云南产气霉与炭角菌科相关类群真菌的系统发育关系。Bootstrap值>50%显示在每个分支的节点上。Creosphaeria sassafras作为外群(袁志林,2010)。
结果分析
1.产孢菌株鉴定
我们对根际壳多孢霉(Stagonosporopsis rhizophilae)的形态特征进行显微观察(图4),梨形或球状至近球状分生孢子器,无毛,无明显的小孔,直径140-280 mm,单生或(2-7)合生不规则形。分生孢子器壁3-7层,外壁由1-3层棕色橄榄色细胞组成。分生细胞呈壶状至球状,透明,光滑,4.0-6.8×5.5-10.0 μm分生孢子多数无菌,透明,椭球形,长圆形或棒状,薄壁,光滑,直径4.2-6.8×1.0-2.6 μm,通常有两个明显的油滴,之后根据分子学鉴定方法构建系统发育树(图8)。
2.非产孢菌株鉴定
产气霉菌落在PDA和MEA培养基上均呈白色(图5),但在MEA培养基上气生菌丝更致密。菌落生长速度中等,在MEA、PDA生长差别不大(表1),25 °C为最适生长温度,在30 °C抑制其生长。25 °C黑暗培养1-3周后,光学显微镜观察并未发现产孢结构和分生孢子,菌丝宽0.8-1.5 μm。
由于产气霉菌株Muscodor yunnanense的不产孢,通过分子学的多基因的系统发育分析对认识其生物学性状是十分重要的。为此,利用ITS和RPB2两个基因片段对产气霉菌株S18-3-1的系统发育关系作了分析(图6,图7)。通过Blast比对,产气霉菌株S18-3-1的ITS序列与GeBank数据库中已报道的Muscodor的5个种序列相似性比较高,其中与M. yucatanensis(FJ917287)的相似性达到98%;而且与炭角菌科中的Xylaria和Nemania等属的序列相似性也较高。但目前数据库中并没有Muscodor属真菌RPB2的序列信息,Blast比对只发现与炭角菌科中的Xylaria和Nemania等属的序列相似性较高。与模式菌株M. albus为参照来分析产气霉菌株S18-3-1和M. albus的系统发育关系。序列分析表明S18-3-1和M. albus的RPB2序列片段的差异达17%。(注:Muscodor sp. S13-1-2也是从野生稻茎杆中分离的,其ITS序列与M. albus 100%相似,RPB2序列与M. albus 99%相似,因此认为与M. albus同种)。
由图6可以看出,基于ITS序列的NJ进化树将Muscodor属真菌划分为3个亚群,其中M. albus、M. crispans和M.roseus 被归类到亚群1(100% bootstrap值支持);M. vitigenus和一个未鉴定到中的Muscodor菌株被归类到亚群2(100% bootstrap值支持);M. yucatanensis和Muscodor sp. S18-3-1被归类到亚群3(85% bootstrap 值支持)。同时也表明,Muscodor属真菌与Xylaria和Nemania等属的亲缘关系较相近,而与炭角菌科的其他属如Daldinia、Annulohypoxylon和Hypoxylon则亲缘关系较远。Muscodor与Xylaria和Nemania等属同属于炭角菌科的Xylarioid亚族,而Daldinia、Annulohypoxylon和Hypoxylon等属同属于炭角菌科的Hypoxyloid亚族。
溶液配方
1.2%麦芽糖提取物培养基(MEA培养基):称取麦芽糖提取物(malt extract, Oxoid)20 g,溶解至适量超纯水中,加入琼脂15 g,定容1 L。121 °C高压灭菌25 min,常温保存。
2.马铃薯胡萝卜培养基(PCA培养基):土豆20 g,胡萝卜25 g,切成小块,加超纯水煮烂(约30 min)后用四层纱布过滤琼脂20 g,定容1L,121 °C高压灭菌25 min(常温保存)。
3.马铃薯培养基(PDA培养基):去皮后马铃薯200 g、切成小块,加超纯水煮烂(约30 min)后用四层纱布过滤,加入葡萄糖20 g,琼脂15 g,定容1 L,PH自然。121 °C高压灭菌25 min(常温保存)。
4.玉米粉培养基:玉米粉琼脂17 g,加1000 ml蒸馏水,煮沸1 min使其完全溶解。121 ºC灭菌15 min,冷却至50 ºC倒平板。
5.OA培养基:Oatmeal Agar 14.5 g,加200 ml蒸馏水,震荡混匀使其溶解,121 ºC灭菌15 min,冷却至50 ºC倒平板。
注:所有的培养基常温冷却至50 °C左右,加入终浓度分别为0.05 g/L和0.02 g/L的硫酸链霉素和盐酸四环素,抑制细菌污染。
6.1×PBS缓冲液:称取10×PBS粉末(上海生工)38.28 g溶于适量超纯水中,定容至4 L。用Na2HPO4调节pH = 7.2,121 °C高压灭菌25 min,4 °C保存备用。
7.50 mg/ml硫酸链霉素溶液(streptomycin sulfate):streptomycin sulfate 2.5 g,超纯水50 ml(室外溶解)。
8.20 mg/ml盐酸四环素溶液:盐酸强力霉素1 g,50%的乙醇溶液50 ml,室外溶解。两种抗生素均进行过滤灭菌:使用无菌注射器吸抗生素溶液,通过孔径为0.45 μm无菌注射过滤器注入无菌烧杯中,再次通过0.22 μm的无菌注射过滤器再次过滤(注意更换滤膜),最后使用2 ml和10 ml的无菌离心管分装,-20 °C保存备用。
9.50×TAE缓冲液配制方法:称量Tris 242 g,EDTA 18.612 g于1 L烧杯中;向烧杯中加入约800 ml超纯水,充分搅拌均匀;加入57.1 ml的冰乙酸,充分溶解;用NaOH调pH至8.3,加去离子水定容1 L后,室温保存。使用时稀释50倍或100倍 即1×TAE Buffer或0.5×TAE
10.1%琼脂糖凝胶配置:称量1 g的琼脂糖,100 ml的1×TAE缓冲液,微波炉加热溶解至无颗粒状物,冷却至50 °C左右,加入绿如蓝核酸染料,混匀后,缓慢倒入磨具,等待冷却。

图8. Stagonosporopsis rhizophilae多基因(ITS, LSU, TUB, RPB2)联合构建系统发育树。分支上的值表示贝叶斯后验概率(左,BI PP≥0.95)和最大自展值(右,ML BP≥50)。研究中描述的菌株用红色字。Allophoma labilis CBS 124.93, All. minor CBS 325.82, Heterophoma adonidis CBS 114309.
参考文献
1.White, T. J., Bruns, T., Lee, S. and Taylor, J.W. (1990). Amplification and direct sequencing of fungal ribosomal RNA genes for phylogenetics. In: PCR Protocols: A Guide to Methods and Applications. (Eds.). Pp, 315-322.
2.Vilgalys, R. and Hester, M. (1990). Rapid genetic identification and mapping of enzymatically amplified ribosomal DNA from several Cryptococcus species. J Bacteriol 172(8): 4238-46.
3.Rehner, S. A. and Buckley, E. (2005). A Beauveria phylogeny inferred from nuclear ITS and EF1-alpha sequences: evidence for cryptic diversification and links to Cordyceps teleomorphs. Mycologia 97(1): 84-98.
4.Liu, Y. J., Whelen, S. and Hall, B. D. (1999). Phylogenetic relationships among ascomycetes: evidence from an RNA polymerse II subunit. Mol Biol Evol 16(12): 1799-808.
5.Aveskamp, M. M., Verkley, G. J., de Gruyter, J., Murace, M. A., Perello, A., Woudenberg, J. H., Groenewald, J. Z. and Crous, P. W. (2009). DNA phylogeny reveals polyphyly of Phoma p Peyronellaea and multiple taxonomic novelties. Mycologia 101(3): 363-82.
6.袁志林. (2010). 疣粒野生稻(Oryza granulata)内生真菌资源挖掘、系统发育分析和功能初探. 浙江大学.
致谢
感谢中国林业科学院中央公益科研院所基金(CAFYBB2020ZY002-1和CAFYBB2019ZA001-3)和国家自然科学基金(No. 31722014)的资助。
猜你喜欢
10000+:菌群分析 宝宝与猫狗 梅毒狂想曲 提DNA发Nature Cell专刊 肠道指挥大脑
文献阅读 热心肠 SemanticScholar Geenmedical
16S功能预测 PICRUSt FAPROTAX Bugbase Tax4Fun
生物科普: 肠道细菌 人体上的生命 生命大跃进 细胞暗战 人体奥秘
写在后面
为鼓励读者交流、快速解决科研困难,我们建立了“宏基因组”专业讨论群,目前己有国内外5000+ 一线科研人员加入。参与讨论,获得专业解答,欢迎分享此文至朋友圈,并扫码加主编好友带你入群,务必备注“姓名-单位-研究方向-职称/年级”。PI请明示身份,另有海内外微生物相关PI群供大佬合作交流。技术问题寻求帮助,首先阅读《如何优雅的提问》学习解决问题思路,仍未解决群内讨论,问题不私聊,帮助同行。

学习16S扩增子、宏基因组科研思路和分析实战,关注“宏基因组”
 点击阅读原文下载PDF审稿,或浏览器直接访问下载链接:http://210.75.224.110/github/MicrobiomeProtocol/04Review/210305/2003661ZhilinYuan952666/Protocol2003661revision.pdf
点击阅读原文下载PDF审稿,或浏览器直接访问下载链接:http://210.75.224.110/github/MicrobiomeProtocol/04Review/210305/2003661ZhilinYuan952666/Protocol2003661revision.pdf























 1151
1151

 被折叠的 条评论
为什么被折叠?
被折叠的 条评论
为什么被折叠?








